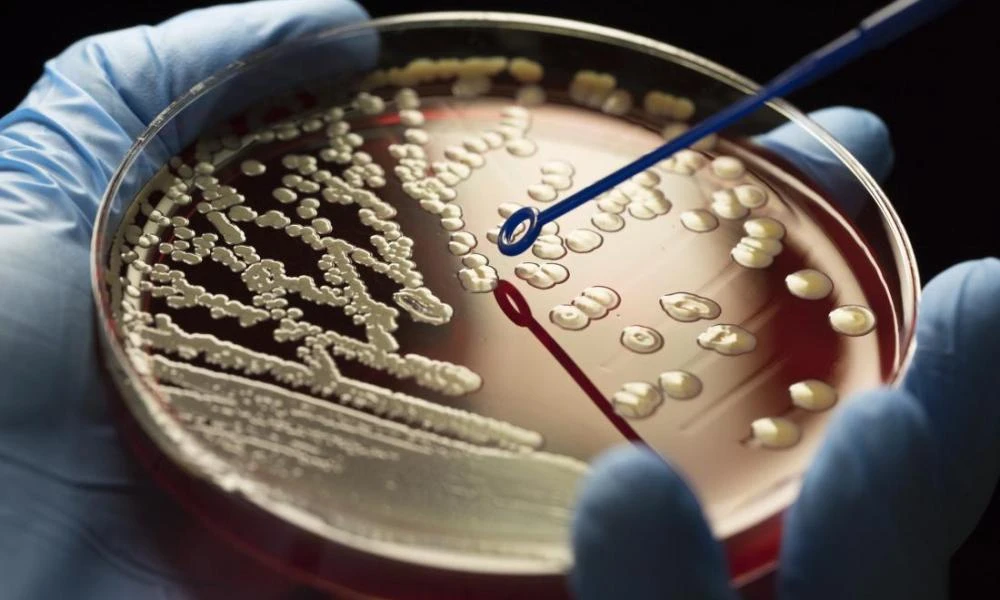
Ανθεκτικά μικρόβια: Θα είναι πιο επικίνδυνα στο μέλλον; Ένας καθηγητής λύνει το μυστήριο

ΥΓΕΙΑ
-
Jun- 2024 -28 JuneΥΓΕΙΑ

Διαβήτης: Δέκα απαραίτητες συμβουλές για το καλοκαίρι
Οι διακοπές του καλοκαιριού αποτελούν ευκαιρία να απολαύσουμε ξανά την ζωή, τη φύση και την εποχή, να χαλαρώσουμε, να ανανεωθούμε και να αποκτήσουμε νέα ενδιαφέροντα.Όσοι όμως ζουν με το διαβήτη στις ...
Read More » -
28 JuneΥΓΕΙΑ

Κορονοϊός: Δυο μέρες μετά τα πρώτα συμπτώματα πρέπει να κάνουμε το τεστ
Τα τεστ που γίνονται αμέσως μετά την έναρξη των συμπτωμάτων κατά κανόνα έχουν λάθος αποτέλεσμα.Η αντίδραση του ανοσοποιητικού συστήματος στην COVID έχει αλλάξει και καλό είναι οι ασθενείς να περιμένου...
Read More » -
27 JuneΥΓΕΙΑ
Ανθεκτικά μικρόβια: Θα είναι πιο επικίνδυνα στο μέλλον; Ένας καθηγητής λύνει το μυστήριο
Μια πρόσφατη έκθεση του Παγκόσμιου Οργανισμού Υγείας (ΠΟΥ) αποκαλύπτει αύξηση του αριθμού των αντιβακτηριακών παραγόντων, συμπεριλαμβανομένων των αντιβιοτικών, από 80 το 2021 σε 97 το 2023. Παρά την α...
Read More » -
27 JuneΥΓΕΙΑ

Πεπόνι: Οκτώ λόγοι για να το εντάξετε στη διατροφή σας
Το πεπόνι, αυτό το μεγάλο φρούτο με τη “δικτυωτή” φλούδα και κιτρινοπράσινη σάρκα, είναι πλούσιο σε βιταμίνες C και A, βήτα-καροτίνη και κάλιο. Είναι επίσης μέτριο σε περιεκτικότητα φυτικών ινών και έ...
Read More » -
27 JuneΥΓΕΙΑ

ΕΦΕΤ: Ανάκληση καπνιστής πέστροφας με παθογόνο μικροοργανισμό
Στην ανάκληση παρτίδας καπνιστής πέστροφας από την αγορά, λόγω παρουσίας του παθογόνου μικροοργανισμού Listeria monocytogenes, προχωρά ο Ενιαίος Φορέας Ελέγχου Τροφίμων (ΕΦΕΤ).Συγκεκριμένα, ο ΕΦΕΤ και...
Read More » -
27 JuneΥΓΕΙΑ

ΕΟΔΥ: 18 νεκροί από κορονοϊό και 487 εισαγωγές σε νοσοκομεία
Τα επιδημιολογικά δεδομένα της τελευταίας εβδομάδας (από 17 έως 23 Ιουνίου) για τη γρίπη, τον κορονοϊό και τον RSV ανακοίνωσε την Πέμπτη, ο Εθνικός Οργανισμός Δημόσιας Υγείας (ΕΟΔΥ).Ιός SARS-CoV2 – λο...
Read More » -
27 JuneΥΓΕΙΑ

Η Ευρωπαϊκή Ένωση είναι η πρώτη χώρα στον κόσμο που ξεκινά εμβολιασμούς για τη γρίπη των πτηνών
Η Φινλανδία πρόκειται να είναι η πρώτη χώρα στον κόσμο που θα χορηγήσει εμβόλια κατά της γρίπης των πτηνών. Η εκστρατεία ανοσοποίησης ξεκινά από την επόμενη εβδομάδα, όπως ανακοίνωσαν την Τρίτη οι υγε...
Read More » -
26 JuneΥΓΕΙΑ

Ροχαλητό: Επιστήμονες προειδοποιούν! Προμηνύει μια πολύ επικίνδυνη νόσο
Το δυνατό ροχαλητό δεν είναι απλώς ηχορύπανση αλλά και ένδειξη προβλημάτων με την πίεση, ισχυρίζεται νέα έρευνα ειδικών σε θέματα ύπνου από Πανεπιστήμιο Flinders, που συμπέρανε όσοι ροχαλίζουν το βρά...
Read More » -
26 JuneΥΓΕΙΑ

Χειροπέδες σε 8 αλλοδαπές που εργάζονταν ως αποκλειστικές νοσοκόμες
Ειδικότερα, κλιμάκιο αστυνομικών διενήργησε ελέγχους, κατά τη διάρκεια των οποίων διαπιστώθηκε ότι 8 αλλοδαπές γυναίκες, εργάζονταν ως αποκλειστικές νοσοκόμες, χωρίς να διαθέτουν το προβλεπόμενο πτυχί...
Read More » -
26 JuneΥΓΕΙΑ

Σε 24ωρη απεργία προχωράει αύριο Πέμπτη ο ΕΟΔΥ
Στην κήρυξη 24ωρης απεργίας για τους εργαζόμενους στον ΕΟΔΥ (σε προγράμματα του ΕΟΔΥ, Κινητές Ομάδες Υγείας, Philos κλπ) για αύριο Πέμπτη, αποφάσισε η ΑΔΕΔΥ προκειμένου να συμμετάσχουν στην προγραμμα...
Read More »
